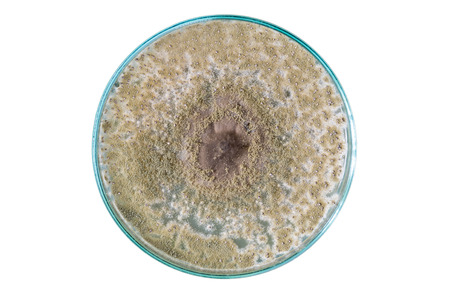

写真素材 - macro of fungi on petri dish isolated on white background
作品情報
macro of fungi on petri dish isolated on white background
- ID:43226027
- 作品種別:写真
- 作者名:kwanchaichaiudom
キーワード
- agar
- antibiotics
- background
- bacteria
- bacterium
- biology
- biotechnology
- close
- colonies
- culture
- disease
- dish
- experiment
- fungi
- genetics
- growth
- health
- hygiene
- isolated
- lab
- laboratory
- macro
- medical
- medicine
- microbiology
- microorganisms
- penicillin
- petri
- plate
- research
- science
- scientific
- sickness
- study
- up
- white background
類似作品
Mushroom wetwoo...
Orange champagn...
Macro photo of ...
small mushrooms...
Wild mushrooms,...
Nature Brown mu...
Mushroom in the...
Colorful mushro...
False morel or ...
close up mushro...
detail of polyp...
Vibrant yellow-...
mushroom in the...
moss forest lit...
Mushroom forest...
Winter mushroom...
Orange mushroom...
Close-up of lar...
a group of oran...
A detailed clos...
poisonous paras...
Nature Brown mu...
An intimate vie...
There are a lot...
A closeup shot ...
White mushrooms...
Macro photo of ...
In autumn after...
Mushroom in the...
Mushroom in the...
mushroom
The beauty of G...
Pleated inkcap ...
Mushrooms in th...
Hypholoma fasci...
Macro photo of ...
Flammulina velu...
yellow mushroom...
Macro of small ...
Generative AI :...
Mushroom rain l...
Pholiota aurive...
agaric mushroom...
a close up of a...
Close-Up of Oys...
Natural Reishi ...
Macro photograp...
mushrooms in th...
pink burn cup o...